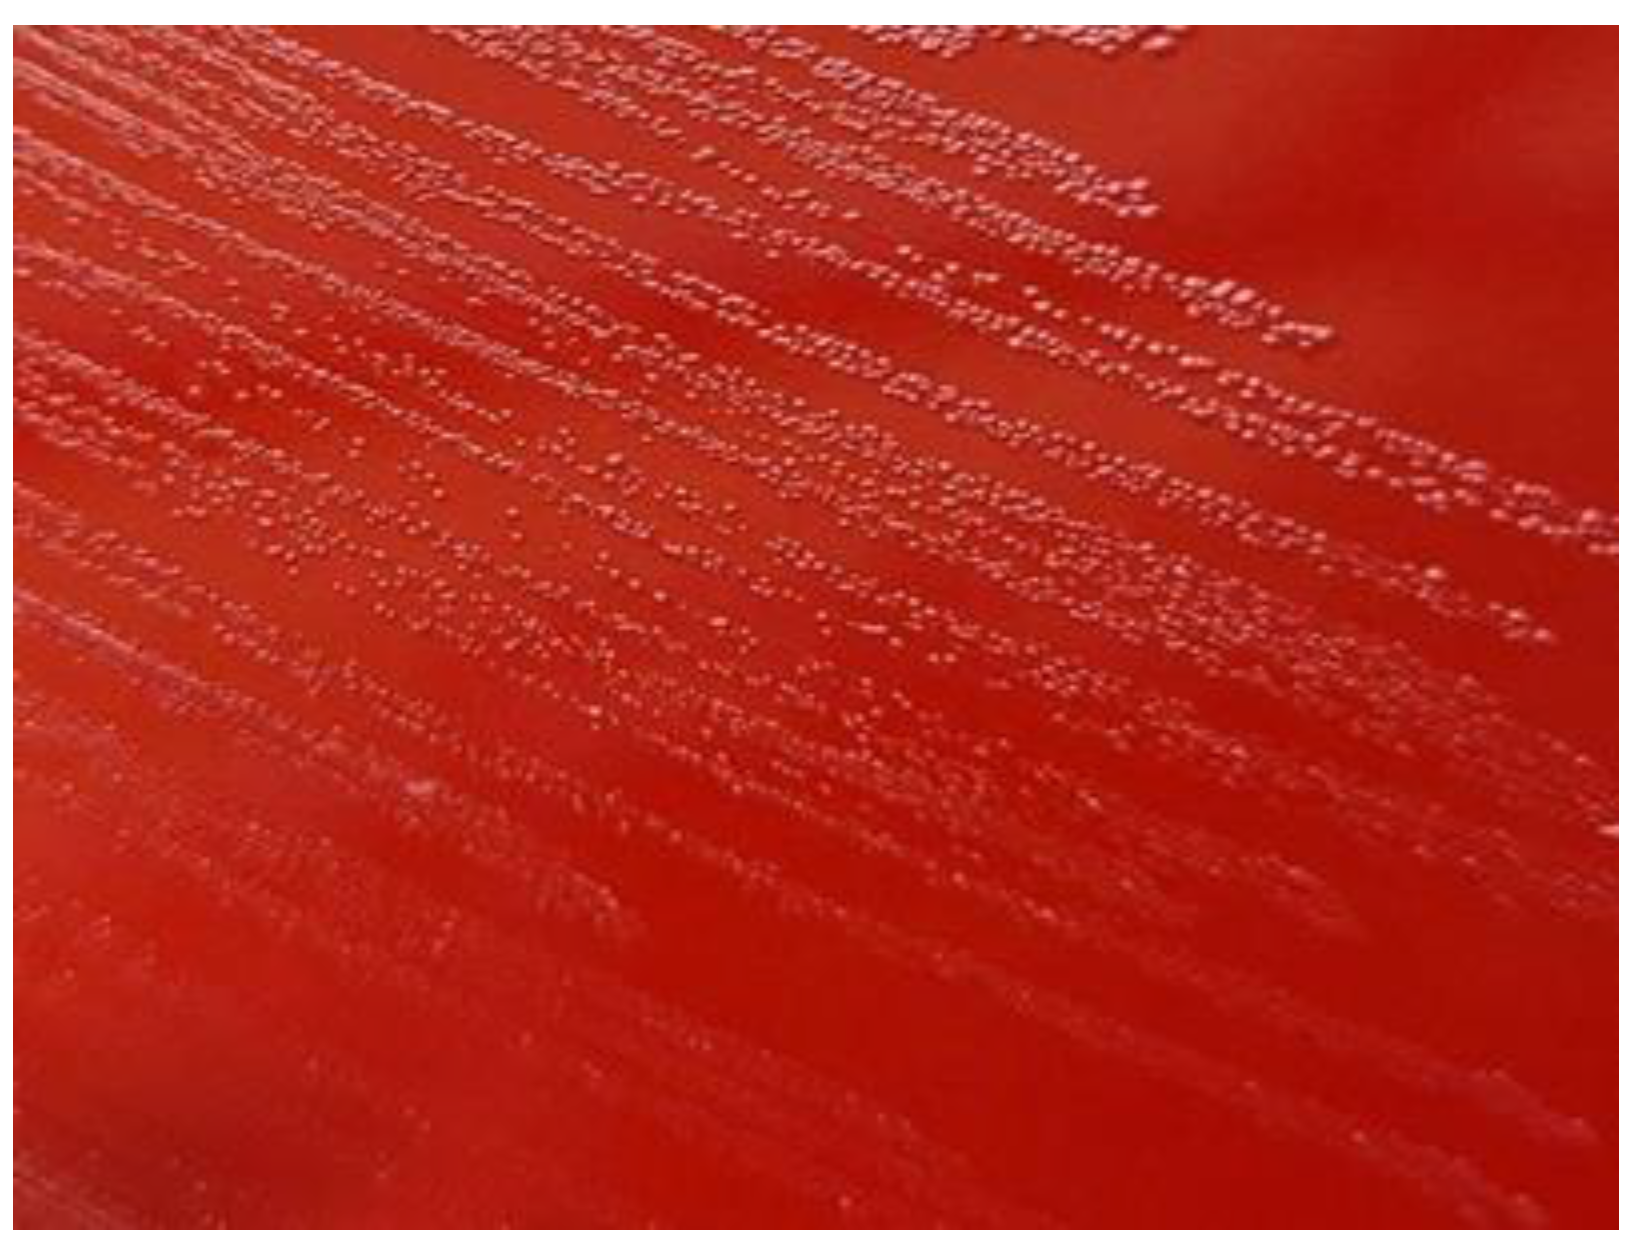
Preprints 164840 g001
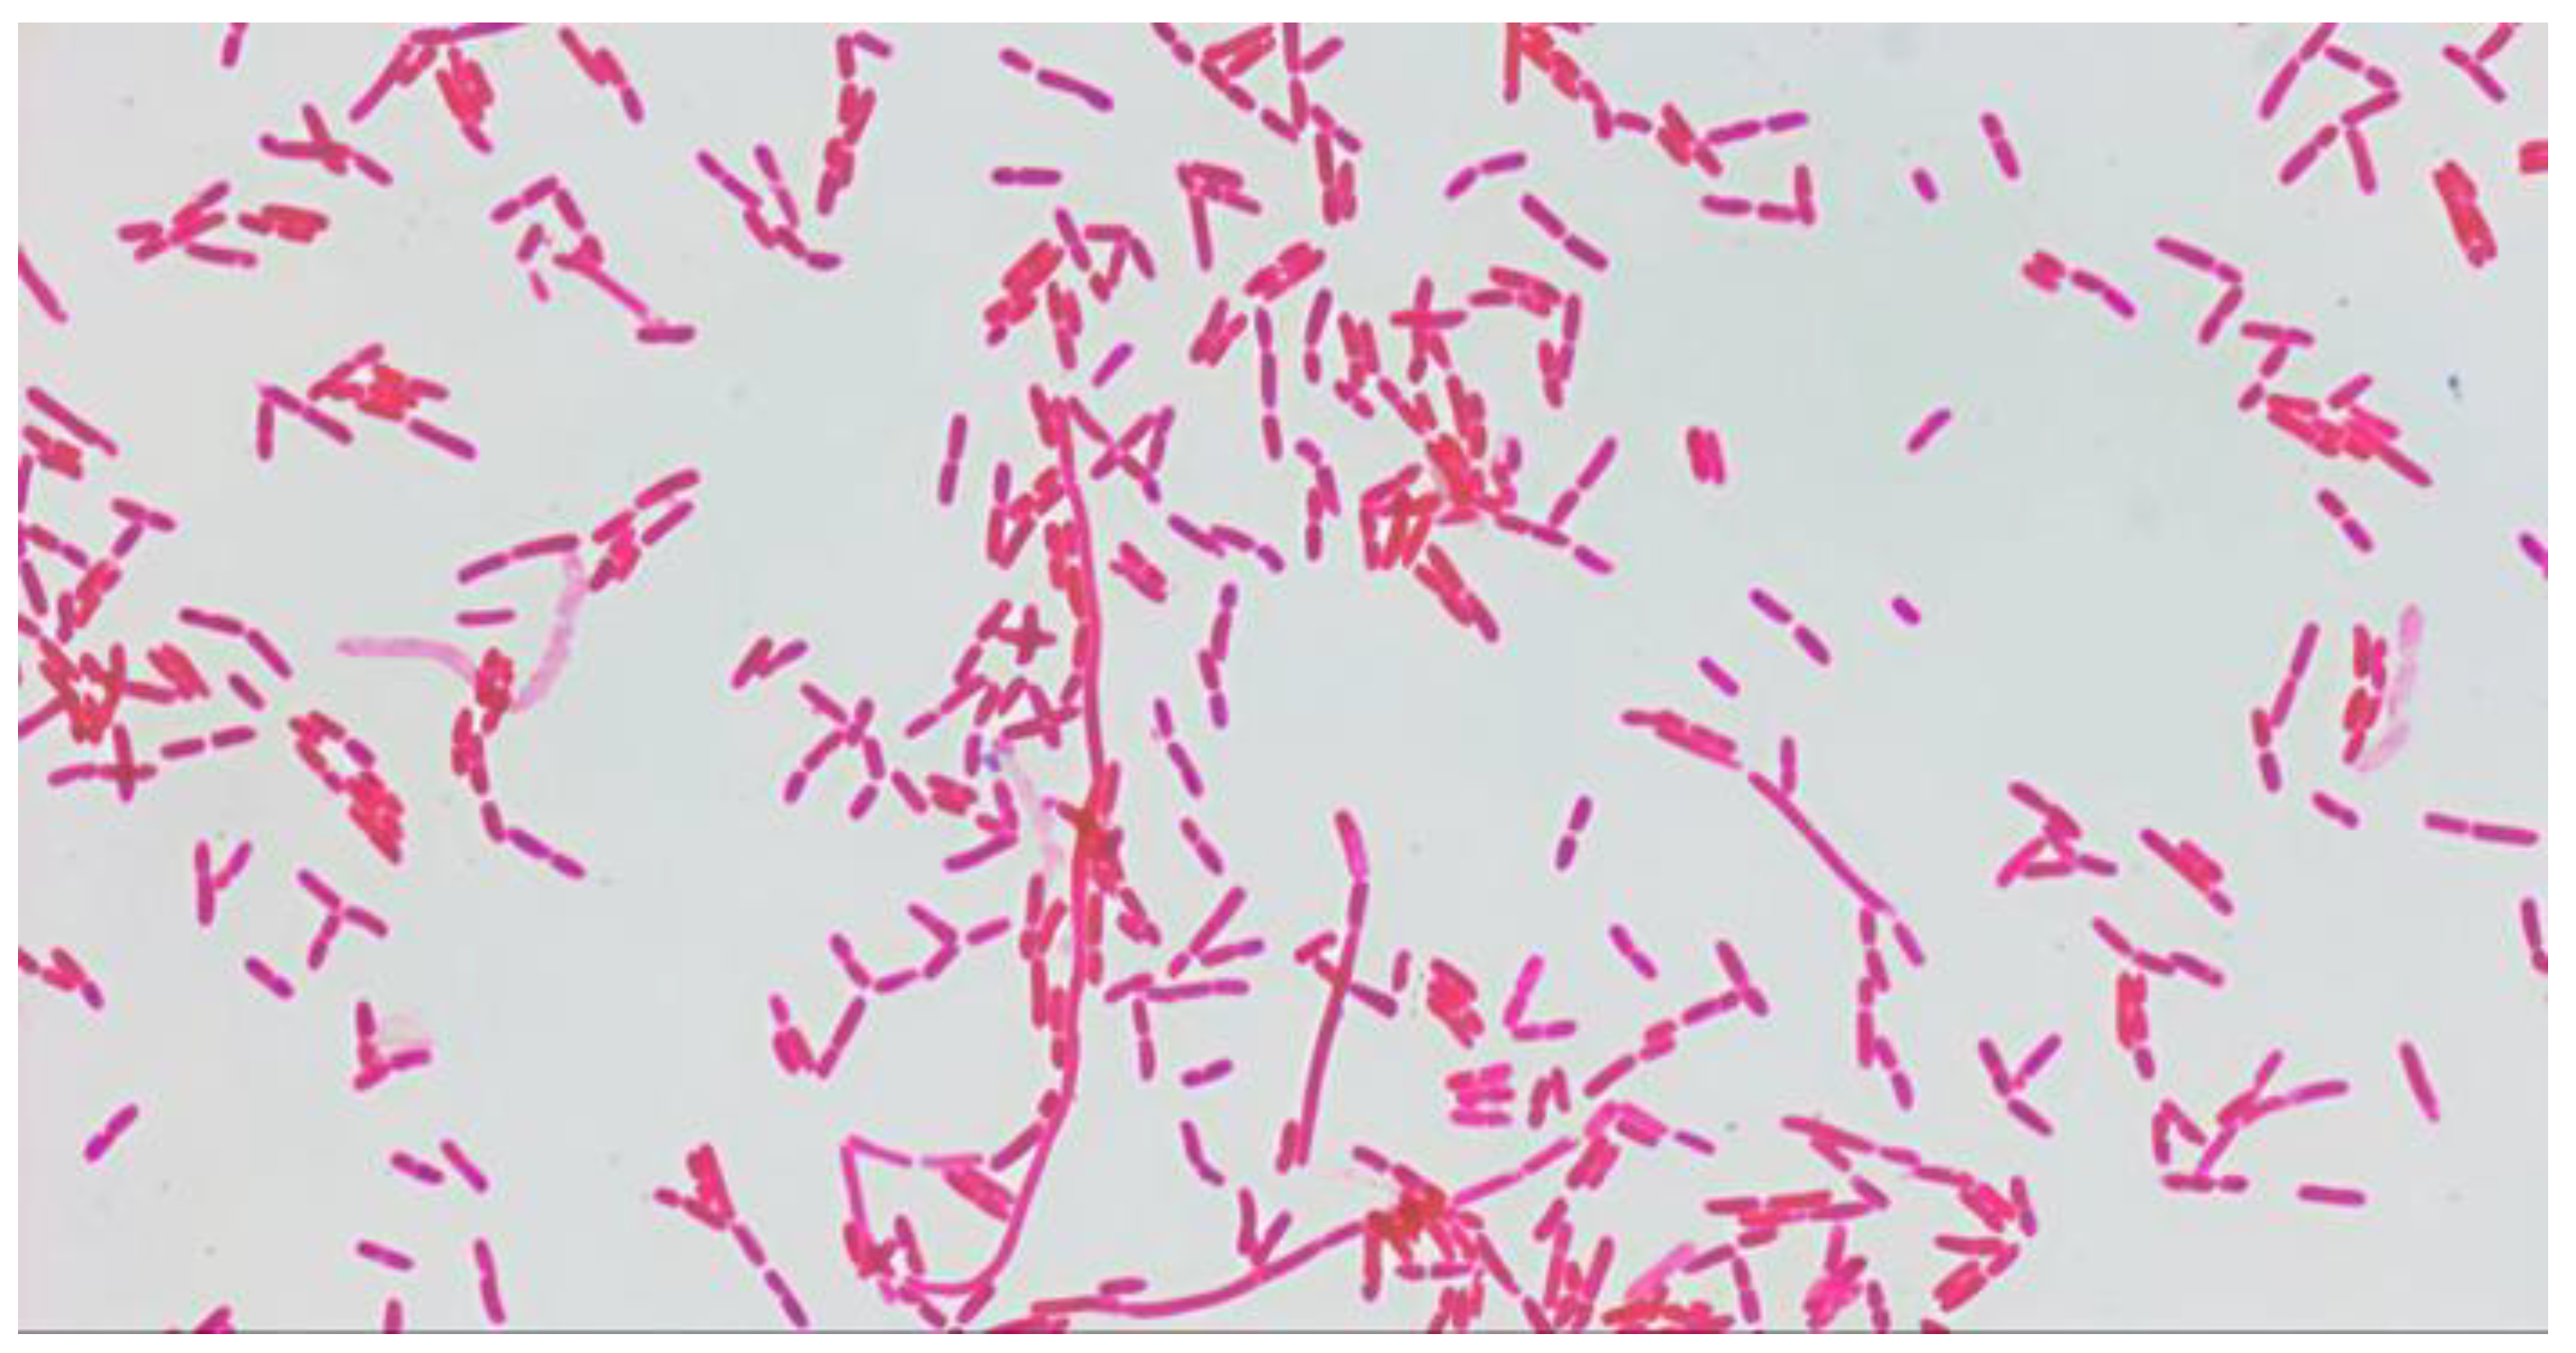
Preprints 164840 g002

1. Introduction
It is currently known that
S. paucimobilis is a glucose-no fermenting Gram-negative bacterium that is widely distributed in both the natural environment and hospitals, an important characteristic of the microorganism for medicine is its high resistance to disinfectants [
1,
2,
3]. The high ability of bacteria of the genus
Sphingomonas to biodegrade organic compounds is known [
4,
5], and the possibilities of using
S. paucimobilis for biomedical and biotechnological purposes are being investigated. Various infections caused by this bacterium in humans have been reported. Most of the reports have been limited to sporadic case reports [
6].
Thus, S. paucimobilis are present in various environments surrounding humans, which causes constant human contact with these microorganisms, so their potential role in the development of human infectious pathology deserves further study.
This study aims to quantify the presence of S. paucimobilis in the fauces microbial landscape of children with recurrent tonsillitis and the sensitivity of isolates to antimicrobials. We specifically investigated how often S. paucimobilis was present in the material obtained from the mucosal membrane of fauces of the children with recurrent tonsillitis and the level of the microbial colonisation of the investigated area by this microorganism. Our findings contributed to more nuanced understanding of the epidemiology of infections caused by this microorganism, and also what antimicrobials can be used for the empirical antibiotic therapy.
The principal conclusions: S. paucimobilis can be transmitted from patients to the environment. Human beings, as well as environmental objects, are likely to be a source of S. paucimobilis. The clavulanic acid-protected β-lactam antibiotics, Piperacillin Tazobactam and Carbopenems, and Rifampicin are the drugs of choice for empirical antibiotic therapy.
2. Materials and Methods
Investigation was conducted at the Department of Paediatrics No 1 with Neonatology, Poltava State Medical University, Poltava, Ukraine, and Department of Microbiology, Virology and Immunology, Poltava State Medical University, Poltava, Ukraine. All samples tested for determination of qualitative and quantitative characteristics of the composition of microorganisms in pathological material obtained from the fauces of children with recurrent tonsillitis in the acute stage. The samples collected from 25 February 2024 to 29 March 2024.
2.1. Study Design and Database
The investigation was carried out following the planned scientific work of the Department of Microbiology, Virology, and Immunology of Poltava State Medical University (PSMU), Ukraine: "Study of the role of opportunistic and pathogenic infectious agents with different sensitivity to antimicrobial drugs in human pathology (No DR 0123 U102413)". The material from the fauces was taken from children with recurrent tonsillitis in the children's outpatient department of the Poltava Regional Clinical Hospital named after M.V. Sklifosovsky. The children were aged from five to eleven years (three girls aged 5, 6, and 8; two boys aged 6 and 11).
2.2. Methods of Investigation
The study was conducted in compliance with biosafety regulations [
7]. The procedures were performed in accordance with the recommendations for basic laboratory procedures in clinical bacteriology [
8]. Material was taken from the fauces with a sterile swab. The stamen probe was placed in Amies transport medium for transportation to the laboratory of the Microbiology, Virology and Immunology Department of PSMU. Columbia agar with 5% sheep blood (bioMarieux, France) was used for primary culture of microorganisms from patients with tonsillitis. The swabs were rubbed over one-quarter of a blood agar plate, and the rest of the plate was streaked with a sterile wire loop from quarter to quarter [
8]. Colonies were streaked on Meat Peptone Agar (MPA) to obtain pure cultures. The cultures were grown for one to three days at 37 °C under aerobic conditions. Morphological and tinctorial properties were determined in the Gram-stained smears. Immersion microscopy was used. The final identification was performed by using the Vitec-2 compact bioMarieux automatic bacteriological analyser (France) according to the manufacturer's instructions with identification cards GP and GN. Cultures of
S. paucimobilis were identified using the GN identification card. Pigmentation of
S. paucimobilis was determined on Columbia agar.
Antimicrobial susceptibility was determined by inhibition zone diameters (EUCAST standardised disk diffusion methodology) on the Mueller-Hinton (MH) agar [
9].
2.3. Data Analysis
To assess the colonisation of the fauces by
S. paucimobilis, a semiquantitative method was used (rare, +, ++, or +++), where massive growth of bacteria with colonies over the entire surface of the plate is +++, growth in the first three quarters is ++, growth in the first two quarters is +, and growth in the first quarter only means rare [
8]. Antimicrobial susceptibility was determined on Mueller-Hinton medium [
6]. The size of the growth retardation zones was measured after 48 hours, given the slow growth of
S. paucimobilis.
The study followed the Helsinki Declaration on Ethical Principles of Medical Research Involving Human Subjects and was approved by the Commission on Biomedical Ethics of Poltava State Medical University (Minutes No 223 of 24.01.2024). At the beginning of the study, each patient signed an informed consent regarding the collection of material for the study, the steps of the study and the possible consequences.
3. Results
3.1. Frequency of Isolation and Assessment of Microbial Colonization
Among the bacteria that grew in the cultures from the fauces, in addition to S. paucimobilis, there were mainly S. aureus. S. pyogenes was not isolated.
Of the samples taken from children with tonsillitis (five children), S. paucimobilis was isolated in 60% of cases (three children). The growth of the general bacterial community was observed in the cultures of all examined sick children in three sectors (++). S. paucimobilis, when was present, was also observed in all three sectors (++). In the material from one child out of three, where S. paucimobilis was present, this species was the most abundant.
3.2. Properties of Isolated Cultures
Colonies of
S. paucimobilis on Columbia agar appeared as small (0.5–1 mm), translucent (
Figure 1).
The growth of S. paucimobilis was slower than that observed for other bacteria. Growth on MPA was slower than that observed on Columbia agar.
The intensity of pigmentation (yellow pigment) varied and was not pronounced in two isolates. More often, the colour of colonies appeared after several days of observation and was light yellow. Colonies of the third isolate had a brownish tint. The last one was characterised by slow α-haemolytic activity.
The growth pattern of colonies of different isolates during subsequent inoculations varied in terms of growth intensity, degree of transparency and strength of attachment to the medium. Re-seeding on MPA often proved to be problematic due to the subsequent slowdown in growth and the difficulty of sufficiently increasing the number of microorganisms for further research. During storage of cultures on MPA, the bacteria were closely adhered to the surface of the medium. The best results were obtained with blood agar streaks.
S. paucimobilis stained by Gram had the form of polymorphic Gram-negative rods, which were located singly, in pairs and, chains (
Figure 2).
3.3. Sensitivity of Isolated Cultures to Antibiotics
There are no cards for determining the antimicrobial susceptibility of
S. paucimobilis using the automated bacteriological analyser Vitek-2 compact bioMerieux (France). It is why antimicrobial susceptibility was determined on Mueller-Hinton medium [
6] by measurement of the growth inhibition zone diameters (EUCAST standardised disk diffusion methodology) on the Mueller-Hinton (MH) agar [
9]. The results of determining the sensitivity of bacteria to antibiotics are presented in
Table 1.
The isolates showed varying susceptibility to different antibiotics, but in general, the bacteria were sensitive to most of them. The diameters of the growth inhibition zones often exceeded 20 mm, sometimes 30 mm. The diameter of the growth inhibition zone of isolate No 1 for Tobramycin was even 40 mm.
The diameters of the growth retardation zones were less than 20 mm for one or more isolates in the case of Ceftazidime, Amikacin, Gentamicin and the combination drug Cotrimoxazole.
The greatest variability in susceptibility was found for the combined drug Cotrimoxazole, when the diameters of the growth retardation zones differed for isolates 1 and 3 by 1.7 times. The cultures were the least sensitive to Aztreonam (the diameters of growth retardation zones were less than 11 mm).
4. Discussion
4.1. Background
The problem of infectious lesions of the human body by opportunistic microorganisms has been relevant for many decades. The list of such microorganisms includes primarily representatives of the genera
Staphylococcus, Streptococcus, Enterococcus, Escherichia, Candida, and others [
4,
5,
6], which can also be found in material taken from healthy people.
S. paucimobilis occupies a special place, because it causes sporadic infections without being included in the list of microorganisms that are in any way associated with the body of a healthy person. Instead, it is known that
S. paucimobilis are microorganisms of the natural environment, in particular soil and water [
10].
4.2. Morphological, Tinctorial, Structural, and Biological Characteristics of S. paucimobilis
S. paucimobilis is an aerobic Gram-negative rod-shaped bacterium with unique characteristics of its outer membranes that distinguish it from many other Gram-negative bacteria. For example, instead of lipopolysaccharides, which are typical for Gram-negative bacteria,
S. paucimobilis contains glycolipids rich in glucuronic acid and sphingolipids instead of lipid A. Some strains of
S. paucimobilis can form a capsule or exopolysaccharides, which promote biofilm formation and survival in adverse conditions [
1,
2,
3]. In our study, we investigated isolates identified as
S. paucimobilis, which matched the morphological, tinctorial, and enzymatic properties reported in the literature. In smears stained by Gram and investigated under immersion microscope, bacteria of the isolates were located singly, in pairs, and chains. (
Figure 2).
According to the literature, this microorganism often (but not always) has a yellow pigment, as it produces carotenoids [
3]. In our studies of
S. paucimobilis we observed two isolates with only slight yellowing cultures on MPA a few days after they were grown in a thermostat and then kept in a refrigerator at +4 °C. Exposure of cultures to natural light did not significantly affect pigment formation. One isolate out of three had a more intense colour of colonies (brownish colour). Both options are consistent with the literature [
3].
4.3. Natural Sources of Infection Caused by S. paucimobilis as One of the Central Issues of Importance in Medical Practice
S. paucimobilis is rather a saprophyte, as it can be found in various environments: water (fresh and marine), soil, plants, and cave walls (several strains have been isolated from samples taken in Romanian caves) [
14]. Thus, according to the generally accepted terminology,
S.paucimobilis infection should be classified as a sapronotic infection by the source of infectious agent (
Figure 3).
4.4. Sources of S. paucimobilis in the Human Habitat in Hospital and Out-of-Hospital Environments
S. paucimobilis is resistant to disinfectants due to the presence of sphingolipids in the outer membrane and the formation of biofilms. This is important in the complex of measures to prevent the occurrence of hospital-acquired infections. Due to these features, it serves as an indicator of disinfection efficiency. Scientific observations of clinical cases focus on the source of infection, as clarity on this issue is the key in the prevention of new cases. However, very often the source of infection remains unclear [
15].
It is known that
S. paucimobilis can be present in hospital environments in dust particles, and can colonise various surfaces, equipment (ventilators, catheters, bronchofibroscopes), water supply systems, etc.) [
16]. A case of isolation of
S. paucimobilis from the surface of children's toys in a paediatric facility has been described [
17]. The important characteristic feature of all these surfaces, which were found to be colonised by
S. paucimobilis bacteria in hospitals, is the fact that they are surfaces of plastic products. Thus, the fact of
S. paucimobilis getting on the mucous membranes of the human fauces of such ubiquitous microorganism should rather be considered as a regularity (
Figure 3).
The high concentration of
S. paucimobilis in pathological material from children with recurrent tonsillitis revealed in our study, and the high percentage of patients with this microorganism indicate a high probability that this microorganism can be transferred from patients to the environment (
Figure 4).
Therefore, a person can become infected not only through contact with environmental objects, but may also be the source from which S. paucimobilis enters the environment. This view is important for a more complete understanding of the specific epidemiology of clinical cases of infection caused S. paucimobilis when no other convincingly proven source has been identified, as is the case with hospital-acquired infections. Human beings, as well as environmental objects, are likely to be a source of S. paucimobilis in both hospital- and community-acquired infections.
4.5. Modes of Transmission in Hospital and Community-Acquired Exogenous Infection Caused by S. paucimobilis. Factors of Transmission
The routes of human infection with S. paucimobilis include iatrogenic, contact and airborne dust.
The literature describes clinical cases of bacteraemia caused by
S. paucimobilis due to intravenous medication [
18] and cases of peritonitis associated with continuous outpatient peritoneal dialysis [
4]. In Korea, cases of co-infection with
S. paucimobilis and
Chryseobacterium indologenes have been reported for this mode of infection [
19].
According to the literature, hospital-acquired infections caused by
S. paucimobilis account for 69.0% of patients with bacteraemia. The majority of them were secondary infected in healthcare facilities as a result of the use of intravascular devices [
5].
Cases of community-acquired infection caused by
S. paucimobilis have also been described, where the source of infection was not identified [
20]. Thus, it is generally accepted that sphingomonas infection is an exogenous sapronous infection by the source of infection in humans. The entry gate is blood, damaged skin, and mucous membranes.
Injectables, medical equipment, instruments and objects surrounding the person, as well as water from water supply systems, can transmit S. paucimobilis. Almost all reported clinical cases of hospital-acquired infections, including iatrogenic infections, include such objects as sources and transmission factors, including plastic.
The literature does not comprehensively describe from which source, through which transmission mechanisms, and due to which transmission factors a patient was infected when the infection was not associated with a hospital stay. As the isolates in our study were from mucosal samples of children treated as outpatients, the possibility of hospital infection did not seem likely. The children also did not attend the same childcare facility outside the hospital and did not belong to the same family, so there were no epidemiological links between individual patients. At the same time, our study found that S. paucimobilis was detected on the pharyngeal mucosa of children with recurrent tonsillitis in 60% of the cases studied. Thus, as in some cases described in the literature, in our investigation it is impossible to identify the source of infection of the examined children with S. paucimobilis bacteria.
4.6. Pathogenicity Factors
No significant pathogenicity factors of
S. paucimobilis have been described in the literature. It is believed that the fundamentally different profile of enzymatic activity compared to other bacteria may be related to the pathogenesis of diseases caused by this microorganism [
4].
The ability to biofilm formation, which was not determined experimentally in our investigation, but manifested as extremely strong adhesion to the surface of MPA when cultures were stored at +4 °C, may also play a role
in vivo. Our observation is consistent with literature data regarding the pronounced adhesive activity of
S. paucimobilis, which is provided by exopolymers of this microorganism [
20].
The low immunogenicity of
S. paucimobilis is determined by the peculiarities of the chemical composition of its outer membranes [
1,
2,
3].
One of our isolates on Columbia agar was characterised by slow α-haemolytic activity. We have not found any information in the literature on the presence of toxins such as haemolysin in S. paucimobilis isolates. We assume that the haemolytic effect of some isolates we found may be the result of the complex action of a wide range of enzymes characteristic of this bacterial species.
No deaths have been reported in the literature related to
S. paucimobilis. However, it is likely that
S. paucimobilis is a more important pathogen than previously thought [
21].
4.7. A susceptible Organism
Knowledge of the role of
S. paucimobilis as an infectious agent is limited, as it is rarely isolated from human pathological material [
16,
17,
18,
19]. The development of generalised or localised infections caused by it and not associated with iatrogenic intervention is considered more likely due to the inability of the immune system to fully protect the body, which arose due to one reason or another, to counteract even a practically non-pathogenic microorganism [
19].
An outbreak caused by
S. paucimobilis in a paediatric haematological and oncological hospital was described, when haemoculture of the pathogen was obtained from samples from 51 patients over a two-year period, when the microorganism was also isolated from water samples from the hot water supply system in this institution [
23]. A case of meningitis caused by
S. paucimobilis and
M. tuberculosis in an immunocompromised patient was also described [
24].
However, in some clinical cases, an atypical infection caused by
S. paucimobilis has been described, when, for example, a 59-year-old immunocompetent patient had a retropharyngeal abscess, and
S. paucimobilis was isolated as a haemoculture [
25]. A case of sphingomonas infection of the eye has also been described [
20]. Thus,
S. paucimobilis can affect both healthy people and people with immunodeficiency. Although this microorganism has a low level of virulence and no deaths have been reported in patients with sphingomonas paucimobilis infection [
26], it can cause septic shock [
4]. The frequent isolation of
S. paucimobilis in our study may be due to both the age-related immune system of children and the fact that these were children with recurrent infection, which in itself is a sign of a decrease in the immune defence.
4.8. Etiotropic Therapy
It is reported in the literature that
S. paucimobilis is usually susceptible to aminoglycosides, fluoroquinolones, aminoglycosides, trimethoprim sulfamethoxazole, and some third-generation Cephalosporins [
1]. In our study, the diameters of growth retardation zones for β-lactam antibiotics were ≥20 mm, and for clavulanic acid-protected antibiotics, this figure was much higher (from 29 to 35 mm for different isolates) and highly variable for different isolates. In addition, the diameters of bacterial growth inhibition were larger for Piperacillin Tazobactam compared to Amoxicillin.
Among the Сephalosporins, Ceftazidime was less effective, with zone diameters of 19 and 18 mm for 2 isolates, respectively. For Ceftriaxone and Cefepime, this figure was at least 23 mm. Thus, the results are consistent with the data reported in the literature [
1]. The results for the Carbopenems varied widely for different isolates – from 20 to 38 mm for Meropenem and from 22 to 36 mm for Imipenem.
The diameters of the zones of no growth for aminoglycosides varied in a wide range – from 15 to 40 mm, depending on the preparation and an isolate. That is, in some cases, this is consistent with the literature, but we found variability in these indicators depending on the isolate.
For Cotrimoxazole, the value ranged from 19 to 32 mm, and for Rifampicin, the value was constant for all isolates (25 mm).
Aztreonam was the least effective, despite the fact that it is considered to be effective in treating infections caused by Gram-negative bacteria such as P. aeruginosa. The reasons for this phenomenon should be sought in the peculiarities of the S. paucimobilis chemical structure and metabolic processes.
Thus, our results of the study of antibiotic susceptibility of isolates indicate a sufficient level of susceptibility of
S. paucimobilis to many antimicrobial agents, as reported in the literature [
1,
2], but also the possible variability of these traits, and, therefore, the possibility of the emergence of more resistant forms. Therefore, the controlled use of antimicrobials is as relevant for the control of
S. paucimobilis as for diseases of other microbial aetiology. According to the results of this study, the clavulanic acid-protected β-lactam antibiotics, Piperacillin Tazobactam and Carbopenems, and in cases of resistance to other antibiotics, the anti-TB antibiotic Rifampicin, are the best drugs of choice for the empirical antibiotic therapy.
5. Conclusions
The obtained results do not confirm or refute the role of S. paucimobilis in microbial associations in the development of infectious pathology of the fauces of children with recurrent tonsillitis. However, it indicates that the presence of this species of microorganisms in the microbial landscape of the pharyngeal mucosa of children with recurrent tonsillitis is a common phenomenon, which, in particular, can be explained by age-related immune system in children.
The high concentration of S. paucimobilis in pathological material from children with recurrent tonsillitis and the high percentage of patients with this microorganism indicate a high probability that this microorganism can be transferred from patients to the environment.
Among the antimicrobials of choice for empirical antibiotic therapy, the best ones are the clavulanic acid-protected β-lactam antibiotics, Piperacillin Tazobactam, and Carbopenems. The anti-TB antibiotic Rifampicin is useful in cases of resistance to other antibiotics.
Author Contributions
Conceptualization, V. F., M. A., and N.H.; methodology, V. F., M. A., T. I., and N.H.; software, V. F., M. A., and N.H.; formal analysis, T. I., N.H., N.B.; investigation, V. F., M. A., and N.H.; resources, T. I., N.H., N.B.; writing—original draft preparation, V. F.; writing—review and editing, V. F., M. A., G.L., T. I., N.H., N.B.; visualization, V. F., M. A; supervision, G.L; All authors have read and agreed to the published version of the manuscript.
Funding
This research received no external funding.
Institutional Review Board Statement
The study was conducted in accordance with the Declaration of Helsinki, and approved by the Commission on Biomedical Ethics of Poltava State Medical University, Ukraine (Minutes No. 223 of 24.01.2024).
Informed Consent Statement
Written informed consent has been obtained from the patients to publish this paper.
Data Availability Statement
The original contributions presented in this study are included in the article. Further inquiries can be directed to the corresponding author.
Acknowledgments
The original contributions presented in this study are included in the article. Further inquiries can be directed to the corresponding author.
Conflicts of Interest
The authors declare no conflict of interest.
References
- Lee, J.U.; Kim, J.K.; Yun, S.H.; Park, M.S.; Lee, N.E.; Sun, I.O.; Lee, K.Y. A Case of Peritoneal Dialysis-Associated Peritonitis Caused by Sphingomonas Paucimobilis. Kidney Res. Clin. Pract. 2013, 32, 78–80. [Google Scholar] [CrossRef]
- Ryan, M.P.; Adley, C.C. Sphingomonas Paucimobilis: A Persistent Gram-Negative Nosocomial Infectious Organism. J. Hosp. Infect. 2010, 75, 153–157. [Google Scholar] [CrossRef] [PubMed]
- Toh, H.S.; Tay, H.T.; Kuar, W.K.; Weng, T.C.; Tang, H.J.; Tan, C.K. Risk Factors Associated with Sphingomonas Paucimobilis Infection. J. Microbiol. Immunol. Infect. 2011, 44, 289–295. [Google Scholar] [CrossRef] [PubMed]
- Fedorchenko, V.I.; Loban, G.A.; Gancho, O.V.; Ivakhniuk, T.V.; Bagnuk, N.A.; Dudar, A.O.; Kovalenko, N.P.; Bobrova, N.O. Modern Trends of Changes in the Microbiota of Urogenital System in Patients with Urolithiasis. Pol. Merkur. Lekarski. 2023, 51, 346–349. [Google Scholar] [CrossRef]
- Yu, F.B.; Shan, S.D.; Luo, L.P.; Guan, L.B.; Qin, H. Isolation and Characterization of a Sphingomonas Sp. Strain F-7 Degrading Fenvalerate and Its Use in Bioremediation of Contaminated Soil. J. Environ. Sci. Health. B. 2013, 48, 198–207. [Google Scholar] [CrossRef]
- Faustova, M.O.; Ananieva, M.M.; Basarab, Y.O.; Dobrobolska, O.V.; Vovk, I.M.; Loban’, G.A. Bacterial Factors of Cariogenicity (Literature Review). Wiad Lek. 2018, 71, 378–382. [Google Scholar]
-
Risk Assessment (Laboratory Biosafety Manual, Fourth Edition and Associated Monographs); World Health Organization: Geneva, 2020; ISBN 978-92-4-001145-8.
- Basic Laboratory Procedures in Clinical Bacteriology; Vandepitte, J. , Verhaegen, J., Engbaek, K., Rohner, P., Piot, P., Heuck, C.C., Eds.; 2nd ed.; World Health Organization: Geneva, 2003; ISBN 978-92-4-154545-7. [Google Scholar]
- EUCAST. The European Committee on Antimicrobial Susceptibility Testing – EUCAST. Available online: https://www.eucast.org (accessed on 24 May 2025).
- Ananieva, M.M.; Faustova, M.O.; Basarab, I.O.; Loban’, G.A. Kocuria Rosea, Kocuria Kristinae, Leuconostoc Mesenteroides as Caries-Causing Representatives of Oral Microflora. Wiad Lek. 2017, 70, 296–298. [Google Scholar] [PubMed]
- Li, Q.; Huang, Y.; Wen, D.; Fu, R.; Feng, L. Application of Alkyl Polyglycosides for Enhanced Bioremediation of Petroleum Hydrocarbon-Contaminated Soil Using Sphingomonas Changbaiensis and Pseudomonas Stutzeri. Sci. Total. Environ. 2020, 719, 137456. [Google Scholar] [CrossRef]
- Lin, J.N.; Lai, C.H.; Chen, Y.H.; Lin, H.L.; Huang, C.K.; Chen, W.F.; Wang, J.L.; Chung, H.C.; Liang, S.H.; Lin, H.H. Sphingomonas Paucimobilis Bacteremia in Humans: 16 Case Reports and a Literature Review. J. Microbiol. Immunol. Infect. 2010, 43, 35–42. [Google Scholar] [CrossRef]
- Bhatia, R.; Tomar, J. Sphingomonas Paucimobilis - an Emerging Pathogen. Int. J. Contemp. Pediatr. 2016, 1123–1125. [Google Scholar] [CrossRef]
- Smalley, D.L. Enzymatic Profile of Pseudomonas Paucimobilis. J. Clin. Microbiol. 1982, 16, 564–565. [Google Scholar] [CrossRef] [PubMed]
- Ionescu, M.I.; Neagoe, D. Ștefan; Crăciun, A.M.; Moldovan, O.T. The Gram-Negative Bacilli Isolated from Caves—Sphingomonas Paucimobilis and Hafnia Alvei and a Review of Their Involvement in Human Infections. IJERPH 2022, 19, 2324. [Google Scholar] [CrossRef] [PubMed]
- Angelakis, E.; Roux, V.; Raoult, D. Sphingomonas Mucosissima Bacteremia in Patient with Sickle Cell Disease. Emerg. Infect. Dis. 2009, 15, 133–134. [Google Scholar] [CrossRef]
- Aleksejeva, V.; Dovbenko, A.; Kroiča, J.; Skadiņš, I. Toys in the Playrooms of Children’s Hospitals: A Potential Source of Nosocomial Bacterial Infections? Children 2021, 8, 914. [Google Scholar] [CrossRef]
- Bayram, N.; Devrim, İ.; Apa, H.; Gülfidan, G.; Türkyılmaz, H.N.; Günay, İ. Sphingomonas Paucimobilis Infections in Children: Nosocomial versus Community Acquired Infections. Mediterr. J. Hematol. Infect. Dis. 2013, 5, e2013040. [Google Scholar] [CrossRef]
- Maragakis, L.L.; Chaiwarith, R.; Srinivasan, A.; Torriani, F.J.; Avdic, E.; Lee, A.; Ross, T.R.; Carroll, K.C.; Perl, T.M. Sphingomonas Paucimobilis Bloodstream Infections Associated with Contaminated Intravenous Fentanyl. Emerg. Infect. Dis. 2009, 15, 12–18. [Google Scholar] [CrossRef]
- Azeredo, J.; Oliveira, R. The Role of Exopolymers in the Attachment of Sphingomonas Paucimobilis. Biofouling. 2000, 16, 59–67. [Google Scholar] [CrossRef]
- Al-Halawani, M.; Dazley, J.; Slim, J.; Boghossian, J. Sphingomonas Paucimobilis Bacteremia in an HIV and Hepatitis C Co-Infected Patient. Ir. J. Med. Sci. 2016, 185, 749–751. [Google Scholar] [CrossRef]
- Zeynali Kelishomi, F.; Mohammadi, F.; Khakpoor, M.; Malekmohammadi, R.; Nikkhahi, F. Isolation of Sphingomonas Paucimobilis from an Ocular Infection and Identification Using Ribosomal RNA Gene: First Case Report from Iran. Clin. Case. Rep. 2023, 11, e7715. [Google Scholar] [CrossRef]
- Souto, A.; Guinda, M.; Mera, A.; Pardo, F. Artritis séptica por Sphingomonas paucimobilis en un paciente inmunocompetente. Reumatología Clínica. 2012, 8, 378–379. [Google Scholar] [CrossRef]
- Aşkın, F.N.; Erinmez, M.; Ören, A.C.; Manay, A.B.; Zer, Y. Sphingomonas Paucimobilis Outbreak a Pediatric Hematology-Oncology Hospital: Epidemiological Investigation and Literature Review of an Emerging Healthcare-Associated Infection. Jpn. J. Infect. Dis. 2022, 75, 374–381. [Google Scholar] [CrossRef] [PubMed]
- Marincu, I.; Bratosin, F.; Bogdan, I.; Dumitru, C.; Stoica, C.N.; Csep, A.N.; Mederle, N.; Fericean, R.M.; Mederle, A.O.; Prathipati, R.; et al. Concurrent Sphingomonas Paucimobilis and Mycobacterium Tuberculosis Meningitis in an Immunocompromised Patient: A Rare Case Report and Comprehensive Review of Literature. Medicina. 2023, 59, 687. [Google Scholar] [CrossRef] [PubMed]
- Tito, E.; Ahmad, A.; Gongolli, J.; Issack, W.; Johnson, A. Sphingomonas Paucimobilis Bacteremia in a Patient With Retropharyngeal Abscess. Cureus. 2022, 14, e25407. [Google Scholar] [CrossRef] [PubMed]
|
Disclaimer/Publisher’s Note: The statements, opinions and data contained in all publications are solely those of the individual author(s) and contributor(s) and not of MDPI and/or the editor(s). MDPI and/or the editor(s) disclaim responsibility for any injury to people or property resulting from any ideas, methods, instructions or products referred to in the content. |
© 2025 by the authors. Licensee MDPI, Basel, Switzerland. This article is an open access article distributed under the terms and conditions of the Creative Commons Attribution (CC BY) license (http://creativecommons.org/licenses/by/4.0/).